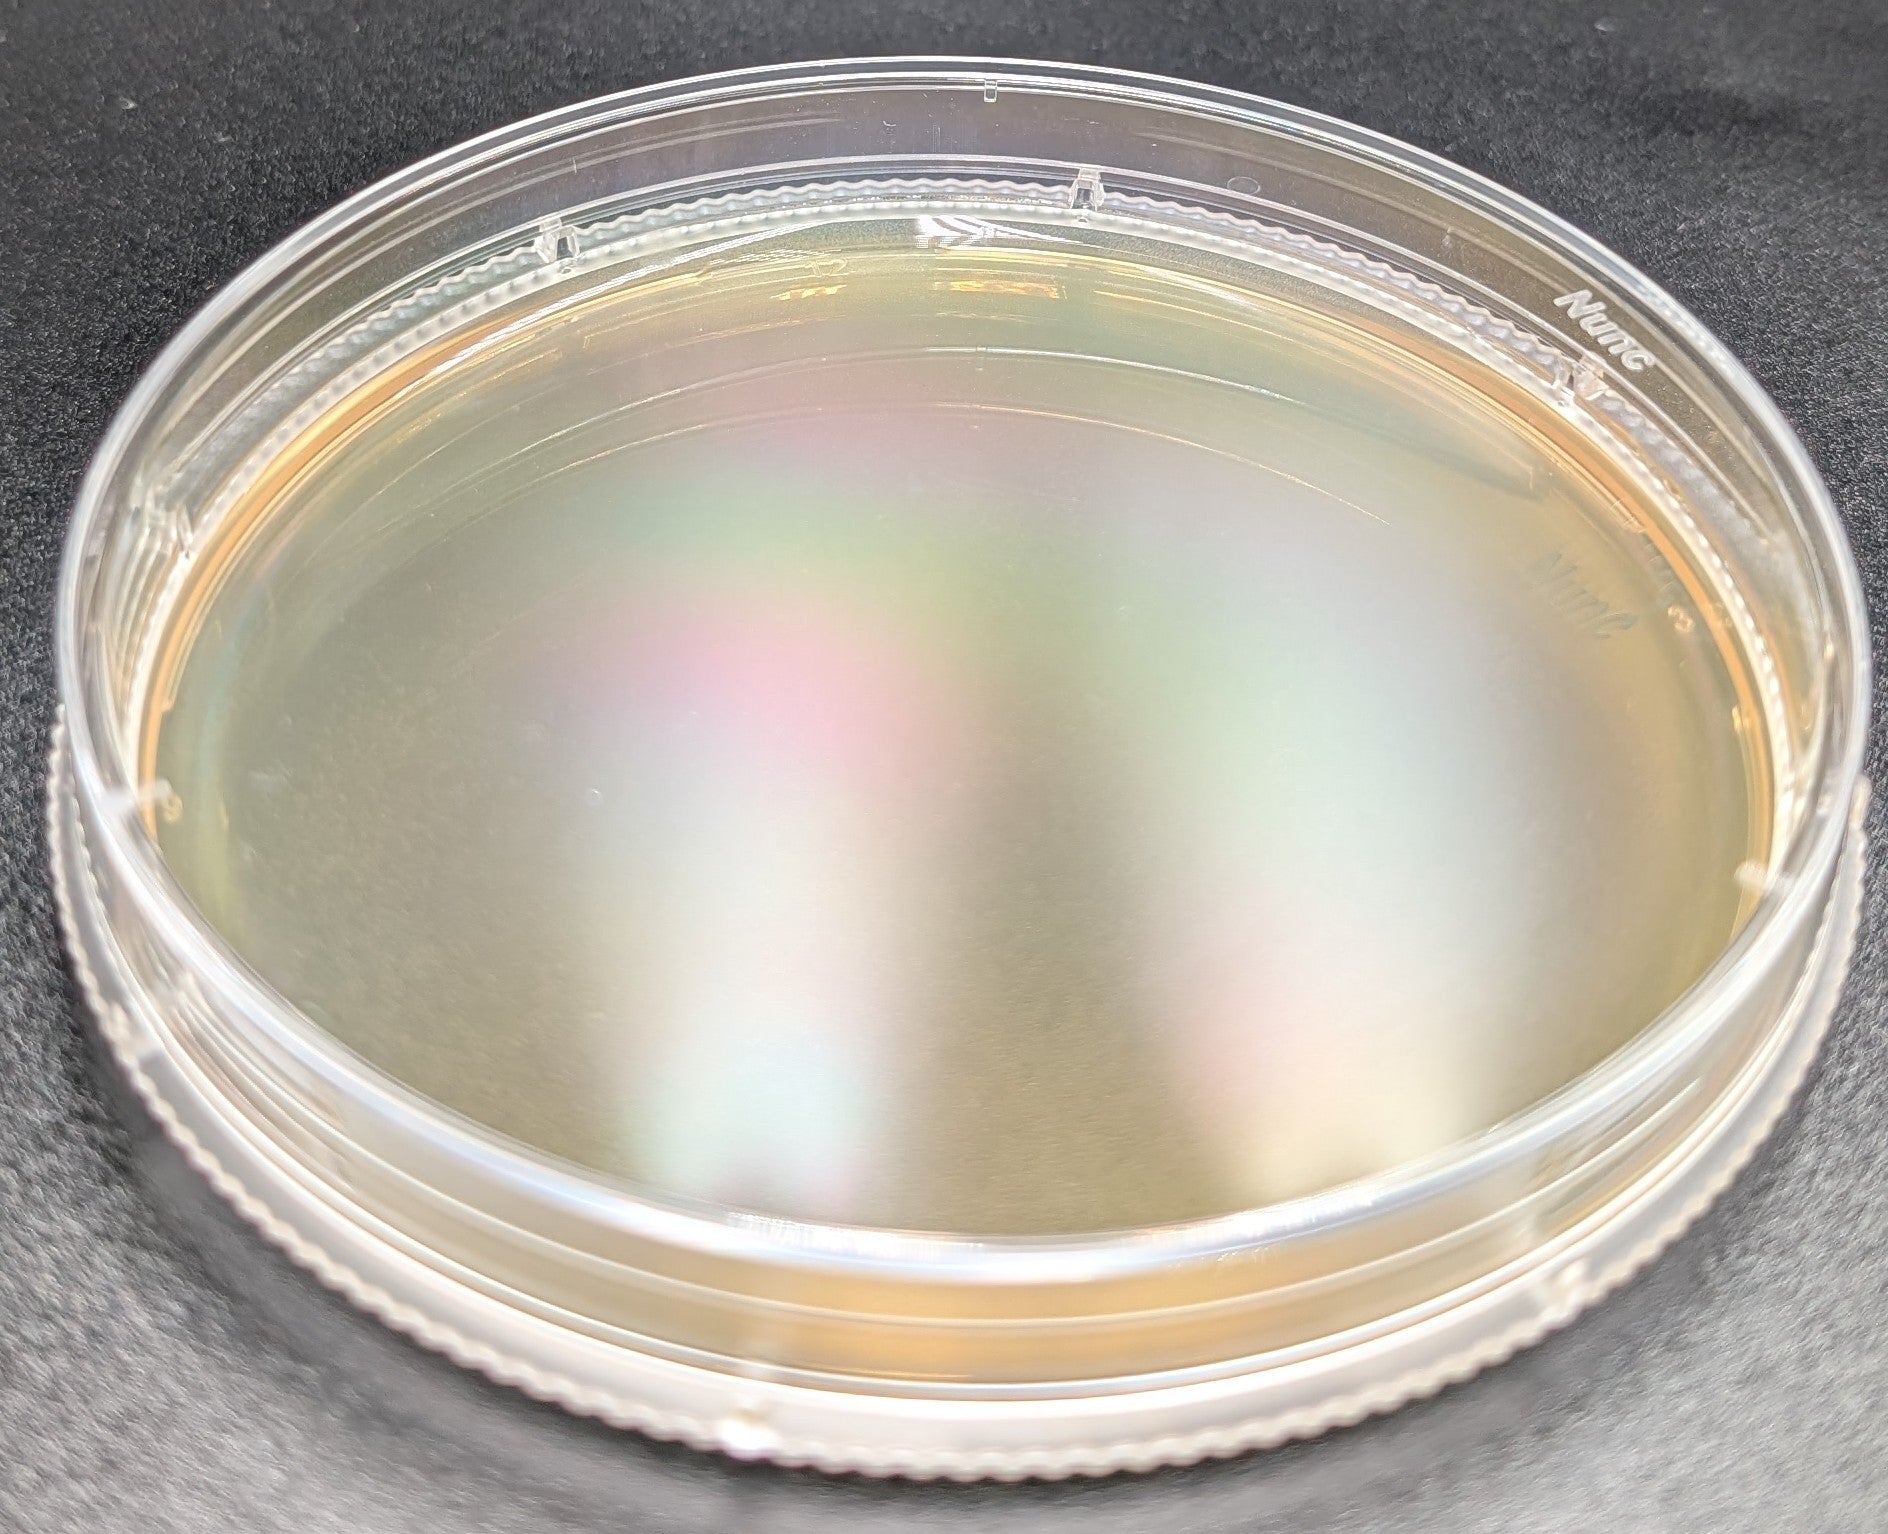

Classic Series - Prepared Agar Plates
The Prover's Choice for Speed & Testing: Mush Ohio's Classic Series.
Meet the drag racer of our agar lineup. Our Classic Series uses a time-tested Sabouraud Dextrose Agar (SDA) formula, which swaps malt extract for pure dextrose—a simple sugar that acts as a high-octane fuel source for mycelium.
Because of its fast energy absorption, this plate is the perfect tool for gauging the speed and aggressiveness of different genetic isolates side-by-side. When you need to know which culture is your fastest, this is the plate you reach for.
Key Features:
- High-Speed SDA Formula: Powered by dextrose for rapid energy uptake, promoting some of the fastest mycelial growth possible.
- The Ultimate Test Medium: The perfect plate for comparing the growth rates and vigor of different isolates to find your strongest performers.
- Crystal Clear & Crisp: Offers a beautiful, crystal-clear, orange-tinted medium for easy viewing and tracking of growth.
Recommended Use:
- Best For: Gauging the aggressiveness of different isolates, speeding up transfers for species like King Trumpets and White Elm, and general fast-growth applications.
- Use With Caution: Like the Vigor series, this rich formula is not recommended for Lion’s Mane.
Our Guarantee:
We stand behind our products. Your Foundation Series agar plates are guaranteed to arrive contamination-free, with the proper agar depth and our precise formula. If you're not satisfied, we'll make it right.
Storage and Handling:
- Store inverted at 65-75°F (18-24°C).
- Avoid direct sunlight.
- Use within 60 days for optimal results.
Shipping:
- Ships Monday-Thursday only in temperature-controlled packaging to ensure viability.
- 24-hour inspection period upon arrival.
Note: Plates utilize culture dishes manufactured by Thermo Scientific™. Mush Ohio is not affiliated with or an authorized distributor of Thermo Scientific™ products. All trademarks are the property of their respective owners.